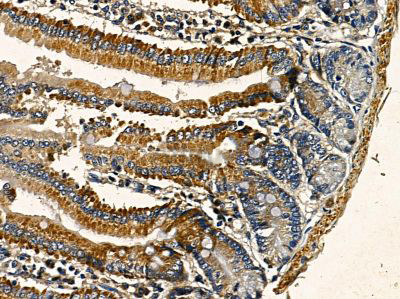

GTPase-activating protein (GAP) for ADP ribosylation factor 1 (ARF1). Hydrolysis of ARF1-bound GTP may lead to dissociation of coatomer from Golgi-derived membranes to allow fusion with target membranes.
Description
Rabbit polyclonal antibody to ARFGAP3
Applications
WB, IF, ICC, IHC.
Immunogen
ARFGAP3 Antibody detects endogenous levels of total ARFGAP3.
Reactivity
Human, Mouse.
可预测:Pig(90%), Zebrafish(%), Bovine(%), Horse(%), Sheep(%), Dog(%), Chicken(%), Xenopus(%)
Molecular weight
57kd,66kDa; 57kD(Calculated).
Host species
Rabbit
Ig class
Immunogen-specific rabbit IgG
Purification
Antigen affinity purification
Full name
ARFGAP3
Synonyms
ADP ribosylation factor GTPase activating protein 1; ADP ribosylation factor GTPase activating protein 3; ADP-ribosylation factor GTPase-activating protein 3; ARF GAP 3; ARFG3_HUMAN; ArfGAP 3; ARFGAP1; ARFGAP3; FLJ45618;
Storage
Rabbit IgG in phosphate buffered saline , pH 7.4, 150mM NaCl, 0.02% sodium azide and 50% glycerol. Store at -20 °C. Stable for 12 months from date of receipt.
Swissprot
Q9NP61




 产品订购:
产品订购:
 渠道电话:
渠道电话: